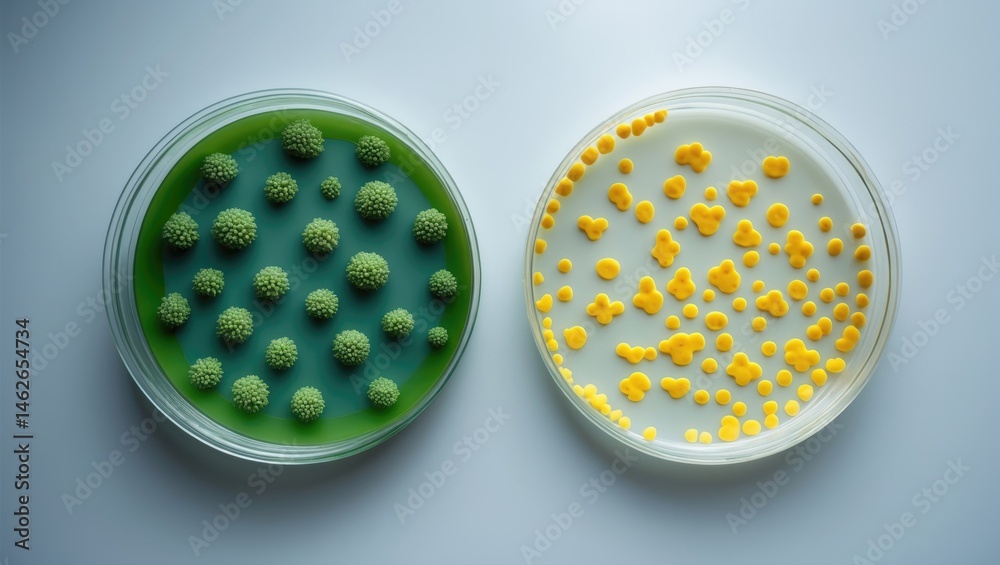
agar-based-comparison-of-bacteria-cultures-gram-negative-comma-shaped

What Is Comma Shaped Bacteria are the perfect service for remaining organized and managing your time successfully. These calendars come in a range of formats, including monthly, weekly, and yearly designs, permitting you to pick the one that fits your planning style. Whether you're tracking appointments, setting objectives, or handling your household's schedule, a printable calendar is a basic yet powerful tool. With personalized styles varying from minimalistic to vibrant themes, there's an option to suit everybody's taste.
Downloading and printing a calendar is quick and problem-free. You can print them at home, work, or a regional shop, making them available anytime you require them. Many templates even consist of pre-marked vacations and unique celebrations, saving you time. Start preparing your days with a What Is Comma Shaped Bacteria and delight in the advantages of a more orderly and productive life!
What Is Comma Shaped Bacteria

What Is Comma Shaped Bacteria
It s always a good time to make a vision board This free printable vision board kit will give you everything you need to make a vision board at home Download the perfect vision board pictures. Find over 100+ of the best free vision board images. Free for commercial use ✓ No attribution required ✓ Copyright-
Vision Board Printable Etsy

Single Comma shaped Bacteria With An Even gram Negative Cell Wall And
What Is Comma Shaped BacteriaCanva's vision board maker makes designing straightforward and easy, with a massive library of editable templates and design elements. A gorgeous new set of FREE vision board printables to get your year started right These pretty designs will motivate you to live your best life every day
This product includes 2 vision board templates, one for children and one for teenagers. The template includes different areas of life that can help guide ... Vibrio Bacteria Shape Spiral Shaped Bacteria
Vision Board Images Download Free Pictures On Unsplash

Vibrio Symposium Emerging Pathogens Institute University Of Florida
Here are some free printable You can right click the image and hit SAVE then print it when you are ready One of these could also work for your mantra Bacteria Sizes
Get inspired with these free vision board printables featuring motivational words and phrases Personalize your vision board and visualize your goals for Bacteria Shapes Bacterial Shapes And Arrangements Diagram Quizlet
![]()
Bacterial Shapes Royalty Free Cartoon CartoonDealer 166430999

Vibrio In The Image You Will See A Number Of Comma Shaped Flickr


Biologa Bacterias

Bacterial Cell
![]()
Types Of Bacteria Basic Morphological Cartoon Vector CartoonDealer

Bacteria Arrangement

Bacteria Sizes
Agar based Comparison Of Bacteria Cultures Gram negative Comma shaped

Rod Shaped Bacteria